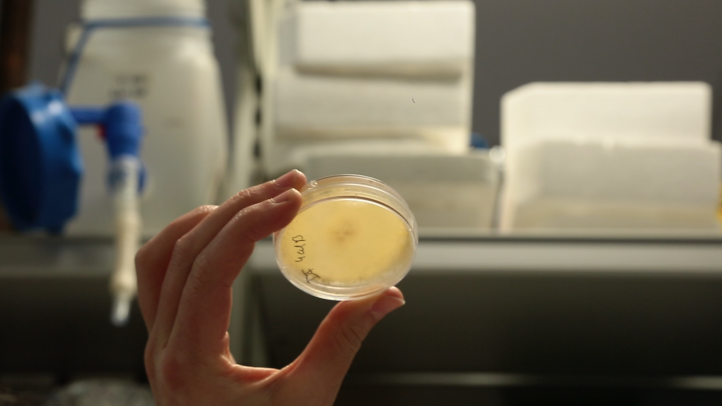
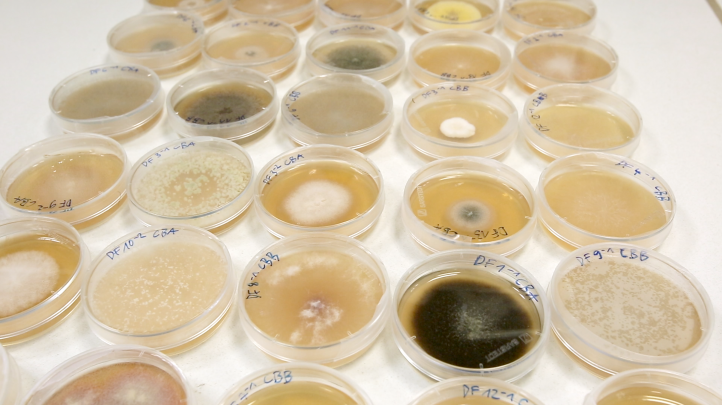

Next » « Previous




terramancy (working title)
–work in progress 2026–
IN COLLABORATION WITH: Rillig Soil Lab, FU Berlin
SUPPORTED BY: Rillig Soil Lab, FU Berlin




IN COLLABORATION WITH: Rillig Soil Lab, FU Berlin
SUPPORTED BY: Rillig Soil Lab, FU Berlin